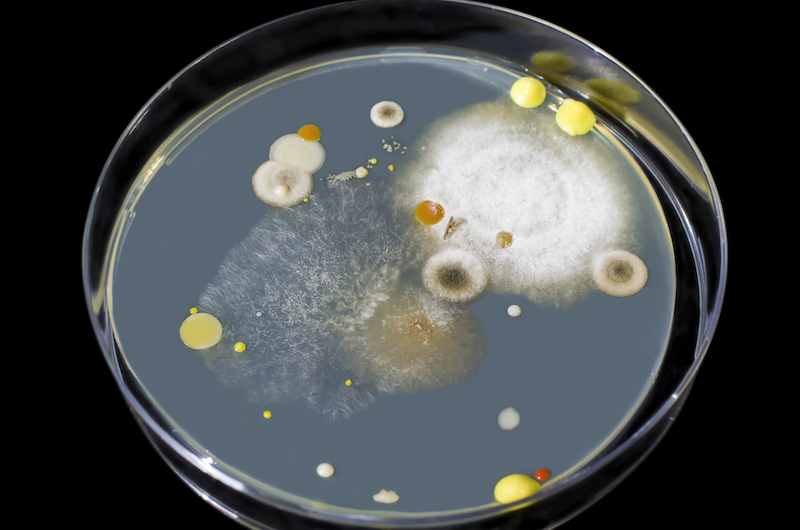
mold growth

Over the years, a growing body of research has developed to understand better the brain, including neurology, the nervous system, and the factors that influence it. One element that’s slowly gaining traction is the state of indoor environments and how contaminants within buildings affect brain health. With the majority of the population spending most of their time indoors and studies reporting that a significant number of buildings have water damage and contamination, it’s easy to see why researchers and society are interested in this relationship. A popular area of interest is the neurological symptoms of mold exposure.
Why Indoor Mold Growth is a Contamination Problem
The over 100,000 species of mold identified in the world thus far reproduce by releasing microscopic spores into the surrounding area.¹’² Like the seeds of a plant, these spores will invisibly float through the air and remain non-living particles until they land on a surface with the necessary components to transition into a living organism.
Typically, spores need two major components for growth: food and moisture.² With water damage on the rise inside buildings and many edible options existing indoors (skin cells, wood, wallpaper, fabric, and other organic materials), it’s relatively easy for colonies to establish inside these environments. Once the living organism puts down roots, it releases microscopic spores into the surrounding environment. Some species also release microscopic toxins called mycotoxins when threatened, further adding to the toxic load.⁴
Thanks to modern building practices pushing for net-zero energy efficiency, there’s minimal airflow between the indoor and outdoor environments. This lack of airflow means that most of the particles released by the mold colony will remain trapped in the home and continue to build up as long as the colony exists in the indoor space hence why exposure to indoor mold growth is a vastly different situation than encountering a colony out in nature, where spores have the entire world to disperse through.
Tying Mold and Health Reactions Together

Mold’s ability to affect health largely rests on the size of the particles in question. Measured in a unit called microns, these particles are small enough to be inhaled, absorbed, and ingested into the body.⁵ Some ultrafine particles are so small that they bypass the body’s defensive systems and go straight into the bloodstream.
As they make their way inside, the body tags the particles as foreign invaders, sparking an immune response to attempt to get them out. This is where the potential for adverse health effects occurs. For some individuals, the immune system is not equipped to deal with the bio-toxins entering the body and cannot properly get rid of them. For others, prolonged exposure can result in the immune system getting overwhelmed, leading to a buildup of toxins within the body. Another concern is that the immune system will malfunction, leading to issues such as chronic inflammation.
The tricky part is that no two people react similarly to exposure. While one individual’s immune system may work in overdrive, resulting in them only developing one reaction, another may get bogged down or malfunction, causing another person to experience over 70 different symptoms.
A long list of factors can influence adverse health reactions in every individual exposed.⁶’⁷’⁸
Some of the factors include:
- Species of mold: Over 100,000 species of mold have been identified so far. Some are pathogenic, while others are naturally toxic
- Genetics: Some individuals are predisposed to be more sensitive to mold exposure. A few studies have started linking those with the HLA-DR as more prone to developing reactions to exposure to mold because their body’s immune system does not respond appropriately to toxins such as mycotoxins.
- Immune system status: Those with a compromised or developing immune system struggle to keep up with how many particles enter the body. Oftentimes, they’ll experience symptoms faster and to a greater extent.
- Presence of mycotoxins: A growing body of research points to the long list of symptoms these toxins can cause. Not all species of mold produce these particles, though, so their presence alongside mold growth varies.
- The length of exposure: More particles will enter the body the longer a person is in that environment. This can eventually lead to an overloaded immune system, adverse health reactions, and toxic buildup.
- The volume of exposure: Similar to the length of exposure, if there’s a significant amount of colonized mold within a home, that means more spores and potentially more toxins and bacteria. This can lead to toxic buildup and adverse health reactions.
- Presence of bacteria: These microorganisms thrive in similar conditions as mold and are often found growing alongside colonies. This adds a layer of complexity to the health impact of exposure.
For many individuals, particularly those hypersensitive, one of the most difficult to handle is the neurological symptoms of mold exposure.
How Do Neurological Symptoms of Mold Exposure Occur?
The issue regarding this indoor contaminant is the lack of research. While various studies show that exposure to mold and mycotoxins affects the body with prolonged exposure in water-damaged buildings, a close enough look hasn’t been given to exactly how and to what extent they can cause damage.⁹’¹⁰’¹¹ The factors mentioned above also play a role in clearly defining these reactions.
Still, a few studies point to various reasons why neurological symptoms of mold exposure develop, particularly for those who are sensitive to mold. Some suggest that toxins in the body can cause mitochondrial dysfunction, triggering neurodegenerative states and symptoms.¹² Others highlight that toxins can compromise the integrity of the blood-brain barrier causing neurological disease.¹³
One of the main drivers of mold’s ability to affect the brain involves inflammation.¹⁴’¹⁵’¹⁷’¹⁸ Typically, inflammation is the body’s biological response to handle injuries and infections to eliminate the cause and begin to repair the damage. Chronic inflammation due to exposure to indoor contaminants can turn this helpful response into a damaging reaction that can trigger issues such as neurological disease and degeneration.
So, what does all that mean? In a nutshell, there are various potential mechanisms for how neurological symptoms of mold exposure could develop, but it depends on various factors. Hence, no two experiences with this indoor contaminant are the same. The important thing to keep in mind is that exposure can trigger these reactions, making it something we should actively work to avoid.
What Are the Neurological Symptoms of Mold Exposure?

Again, every experience of exposure is different. Some individuals may not experience neurological symptoms, while others may develop multiple.
Some of the common neurological symptoms of mold exposure include:
- Brain fog
- Chronic fatigue
- Mood swings
- Anxiety and depression
- Light sensitivity
- Concentration issues
- Headaches
- Behavioral changes
- Dizziness and difficulty balancing
Exposure can also lead to autoimmune diseases, many of which can result in neurological symptoms in those who are hypersensitive. An increasing number of studies are linking it to neurological disorders as well.¹⁹’²⁰’²¹’²²
Some of these include:
- Chronic Inflammatory Response Syndrome
- Autism
- Alzheimer's
- Hashimoto's
- Multiple sclerosis
Again, not all mold exposure will trigger neurological symptoms or related diseases, and not all neurological symptoms or associated diseases are caused by mold exposure. And, because exposure can trigger a multisystemic response, adverse health reactions can span the entire body, making initial diagnosis difficult.
However, the potential for this relationship to develop exists, making it a situation that we should all work to be informed about. No one wants to develop neurological symptoms due to living in a toxic environment.
What to Do if You Suspect Neurological Symptoms of Mold Exposure
The first step towards addressing the neurological symptoms of mold exposure is to determine if microbial growth is causing those reactions.
Check for Signs
Any home can develop a mold problem. More and more brand-new homes have contamination issues before anyone ever moves inside. This is due to a lack of awareness and consideration for avoiding microbial growth throughout the building process. On the other hand, older homes can have various structural issues, allowing for moisture intrusion and microbial growth.
Signs of microbial growth can include:
- Visible growth: There are over 100,000 species of mold identified around the world so far. With so many in existence, mold can come in various colors, shapes, and textures. Some of the most common colors include green, pink, white, grey, blue, red, black, brown, or a combination of hues. As for textures, they could be fuzzy, powdery, velvety, or slimy.
- Odor: Growth can create an earthy, musty, damp, cigar-like smell due to the release of gases called microbial volatile organic compounds (MVOC).
- Water damage: This creates the perfect conditions for microbial growth to develop, so it should always be a factor for potential contamination if it's present.
Test the Body and Work With a Knowledgeable Doctor
There’s no singular test for determining if there are high levels of toxins from mold exposure in the body. A qualified medical professional familiar with mold will be able to run a series of tests that can help alert them to environmental exposure as the root cause of the problem or part of the issue. This includes blood work, mycotoxin testing, visual contrast sensitivity, and genetics.
Remember, though, that not all medical professionals know mold’s ability to impact the body and how to treat it.
The medical professional you are working with should understand this issue. They should have experience treating clients with environmental exposures and have a process to figure out precisely what your body needs to heal. They're not the professionals for you if they suggest a single "fits-all" strategy.
This individual should also listen to you, trust in your instincts, and be dedicated to doing whatever it takes to help you and your family heal. Unfortunately, getting through mold exposure can be a difficult and time-consuming process. They should be in it for the long haul, ready to face any obstacles that may pop up, and shape their protocol around wherever you are in the home health process.
Test the Space
The best way to determine if there’s mold in a home is to hire a qualified mold inspector. This individual will be able to determine if there’s mold growth in a house, what species are present, where the colony or colonies are, what the contamination levels are, and what caused the growth in the first place. Their inspection should span a few hours, thoroughly check every space in the house, and use various measuring techniques to assess the area.
Some of the testing data you should expect to see are:
- Species of mold present
- Quantities of each mold
- Potential spore presence in the HVAC system
- Presence of mycotoxins
- Presence of bacteria
All of this information is needed to understand what exists in the home so that they can create the right protocol for the unique situation. If other contaminants, such as mycotoxins and bacteria, are present, the remediation protocol must address this. Should spores make their way into the HVAC, this must be remedied. Otherwise, those particles will blow all over the home and could turn into a new mold colony.
Successful remediation requires every puzzle piece to fit together correctly to decontaminate a home.

If you’re not ready to hire a mold inspector, consider an at-home testing alternative such as The Dust Test. Microscopic contaminants will collect where dust collects. Testing and analyzing indoor dust will help determine if there are high amounts of contaminants in the dust, which points to a current issue within the home.
Was Mold Found?
If the testing data shows mold in the home, your next step is to find a qualified remediation company like HomeCleanse to remove it. Like mold inspectors, though, not all remediation teams are built the same.
You want a company that prioritizes your health, understands the importance of creating a safe environment, and has proven success in remediating toxic homes. Their protocol should be built on three main pillars to ensure proper decontamination.
These three pillars are:
- Remediate the sources properly.
- Identify and address the problems that led to those sources in the first place.
- Eradicate all contamination created by those sources, including toxins and bacteria.
Failure to hit every point is an unsuccessful remediation.
If the source that led to the contamination isn’t addressed, the conditions for growth are still there, allowing the problem to come right back. Should the roots of the microbial growth be left behind, the colony can come right back. High amounts of contaminants like mycotoxins and bacteria left behind can lead to continued exposure. Each scenario does not lead to a healthy home environment and can allow chronic symptoms to persist.
The last thing anyone wants to do is waste money and time repeating the process while continuing to feel ill. The right team should check all the above boxes so that when they leave, you can rest easy knowing that the mold on the bathroom ceiling is no longer an issue.
Focusing on Wellness

Recognizing the prevalent neurological symptoms associated with mold exposure is crucial for fostering awareness. Considering the substantial time spent indoors, breathing quality air significantly influences our continuous health and overall well-being. If you experience any of the symptoms above without a clear diagnosis from medical professionals, it may be linked to exposure to indoor contaminants. The sooner that underlying culprit is found, the faster someone can jump into healing.
There's no need to accept a life with persistent health issues when the culprit may reside within our homes. Taking steps to eliminate microbial growth, conducting thorough space decontamination, and detoxifying can pave the way for your body's healing journey.
Also, engaging in a conversation about indoor air quality and the common neurological symptoms of mold exposure isn’t a pessimistic dialogue. Shedding light on this subject is designed to empower you! The more knowledge you gain about the impact of environmental exposures on health, the more you can enhance your overall well-being.
If you have questions, don’t hesitate to contact experts and discuss your concerns or uncertainties.
- Environmental Protection Agency. (n.d.). Mold. EPA. Retrieved from https://www.epa.gov/mold.
- Centers for Disease Control and Prevention. Basic facts about mold and dampness. Centers for Disease Control and Prevention. Retrieved from https://www.cdc.gov/mold/faqs.htm.
- World Health Organization. (n.d.). Mycotoxins. World Health Organization. Retrieved from https://www.who.int/news-room/fact-sheets/detail/mycotoxins.
- Tsongas, G. A., & Riordan, F. (2016). Minimum conditions for visible mold growth. ASHRAE Journal, 58(9), 32.
- Nchh. (n.d.). Mold. NCHH. Retrieved from https://nchh.org/information-and-evidence/learn-about-healthy-housing/health-hazards-prevention-and-solutions/mold/
- Bush, R. K., Portnoy, J. M., Saxon, A., Terr, A. I., & Wood, R. A. (2006). The medical effects of mold exposure. Journal of Allergy and Clinical Immunology, 117(2), 326-333
- Wild, C. P., & Gong, Y. Y. (2010). Mycotoxins and human disease: a largely ignored global health issue. Carcinogenesis, 31(1), 71-82.
- Fisk, W. J., Lei-Gomez, Q., & Mendell, M. J. (2007). Meta-analyses of the associations of respiratory health effects with dampness and mold in homes. Indoor air, 17(4), 284-296.
- Andersen, B., Frisvad, J. C., Søndergaard, I., Rasmussen, I. S., & Larsen, L. S. (2011). Associations between fungal species and water-damaged building materials. Applied and environmental microbiology, 77(12), 4180-4188.
- Harding, C. F., Pytte, C. L., Page, K. G., Ryberg, K. J., Normand, E., Remigio, G. J., ... & Abreu, N. (2020). Mold inhalation causes innate immune activation, neural, cognitive and emotional dysfunction. Brain, behavior, and immunity, 87, 218-228.
- Empting LD. Neurologic and neuropsychiatric syndrome features of mold and mycotoxin exposure. Toxicol Ind Health. 2009 Oct-Nov;25(9-10):577-81. doi: 10.1177/0748233709348393. PMID: 19854819.
- Julian Pardo, Christin Urban, Eva M. Galvez, Paul G. Ekert, Uwe Müller, June Kwon-Chung, Mario Lobigs, Arno Müllbacher, Reinhard Wallich, Christoph Borner, Markus M. Simon; The mitochondrial protein Bak is pivotal for gliotoxin-induced apoptosis and a critical host factor of Aspergillus fumigatus virulence in mice . J Cell Biol 14 August 2006; 174 (4): 509–519. doi: https://doi.org/10.1083/jcb.200604044
- Obermeier, B., Daneman, R., & Ransohoff, R. M. (2013). Development, maintenance and disruption of the blood-brain barrier. Nature medicine, 19(12), 1584–1596. https://doi.org/10.1038/nm.3407
- Hyvönen, S., Lohi, J., & Tuuminen, T. (2020). Moist and mold exposure is associated with high prevalence of neurological symptoms and MCS in a Finnish hospital workers cohort. Safety and health at work, 11(2), 173-177.
- Julian Pardo, Christin Urban, Eva M. Galvez, Paul G. Ekert, Uwe Müller, June Kwon-Chung, Mario Lobigs, Arno Müllbacher, Reinhard Wallich, Christoph Borner, Markus M. Simon; The mitochondrial protein Bak is pivotal for gliotoxin-induced apoptosis and a critical host factor of Aspergillus fumigatus virulence in mice . J Cell Biol 14 August 2006; 174 (4): 509–519. doi: https://doi.org/10.1083/jcb.200604044
- Patel, R., Hossain, M. A., German, N., & Al-Ahmad, A. J. (2018). Gliotoxin penetrates and impairs the integrity of the human blood-brain barrier in vitro. Mycotoxin research, 34(4), 257-268.
- Devoto, C., Arcurio, L., Fetta, J., Ley, M., Rodney, T., Kanefsky, R., & Gill, J. (2017). Inflammation relates to chronic behavioral and neurological symptoms in military personnel with traumatic brain injuries. Cell transplantation, 26(7), 1169-1177.
- Degan, D., Ornello, R., Tiseo, C., Carolei, A., Sacco, S., & Pistoia, F. (2018). The role of inflammation in neurological disorders. Current pharmaceutical design, 24(14), 1485-1501.
- Pizzorno, J., & Shippy, A. (2016). Is Mold Toxicity Really a Problem for Our Patients? Part 2-Nonrespiratory Conditions. Integrative medicine (Encinitas, Calif.), 15(3), 8–14.
- Kraft, S., Buchenauer, L., & Polte, T. (2021). Mold, Mycotoxins and a Dysregulated Immune System: A Combination of Concern?. International Journal of Molecular Sciences, 22(22), 12269.
- Shoemaker RC, House D, Ryan J, Vasoactive intestinal polypeptide (VIP) corrects chronic inflammatory response syndrome (CIRS) acquired following exposure to water-damaged buildings. Health, 2013;5 (3): 396-401
- Milani, K. (2017). Chronic inflammatory response syndrome diagnosis and treatment.
- Bredesen, D. E. (2016). Inhalational Alzheimer's disease: an unrecognized—and treatable—epidemic. Aging (Albany NY), 8(2), 304.
Still Have Questions?
A member of our team is here to help! Click on “Get Started ➤” below to book a consultation with a member of the HOMECLEANSE team. We have a few quick questions that will help us put together a roadmap to solve or prevent all of your mold problems.
Two minutes of your time could lead to better health for you and your family.









